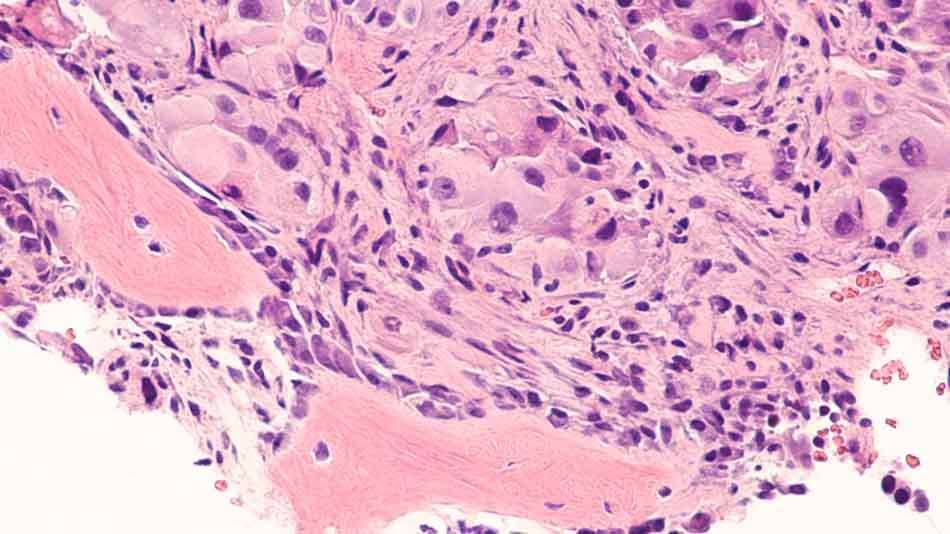

Kemik Metastazı: Belirtileri, Tedavisi ve Yeni Gelişmeler
Kemik Metastazı: Belirtileri, Tedavisi ve Yeni Gelişmeler
Kemik metastazı görülme sıklığı artıyor. Acıbadem Fulya Hastanesi’nden Doç. Dr. Seyit Ali Gümüştaş, tedavideki yeni gelişmeleri anlattı.
Halk arasında ‘kanserin kemiğe sıçraması’ olarak bilinen kemik metastazının görülme sıklığı günümüzde giderek yaygınlaşıyor. Son yıllarda kanser tedavilerinin gelişimine paralel olarak yaşam süresi uzadıkça metastatik kemik kanseri ile çok daha fazla karşılaşıldığını belirten Acıbadem Fulya Hastanesi Ortopedi ve Travmatoloji, Ortopedik Onkoloji Uzmanı Doç. Dr. Seyit Ali Gümüştaş “ Kemik metastazı mevcut kanserin ilerlediğini gösterir. Akciğer ve karaciğerden sonra en sık metastaz alan üçüncü bölgedir. Kanser tipine bağlı olarak kemik metastazının görülme sıklığı yüzde 70’i bulabilmektedir” diyor. Hastaların en sık başvuru nedeninin şiddetli ağrı, şişlik, topallama ve kemikte kırık olduğunu, bu nedenle bu tür şikayetlerin ihmal edilmemesi gerektiğini vurgulayan Doç. Dr. Seyit Ali Gümüştaş kemik metastazı hakkında bilinmesi gerekenleri ve tedavide yeni gelişmeleri anlattı, önemli uyarılar ve önerilerde bulundu.
Bu belirtilerle kendini gösterebiliyor!
Son yıllarda kanser tedavilerinin gelişimine paralel olarak yaşam süresi uzadıkça metastatik kemik kanseri ile karşılaşma sıklığı da artıyor. Genellikle yavaş seyirli ilerleyen, iyi ve kötü huylu olmak üzere ikiye ayrılan kemik tümörlerinde hastaların sıklıkla ağrı şikayetiyle hekime başvurduğunu, ağrıda belirleyici unsurun ise istirahatta bile devam etmesi ve zamanla şiddetinin artması olduğunu belirten Doç. Dr. Seyit Ali Gümüştaş “Hasta geceleri ağrı nedeniyle uykudan uyanabilir ve standart ağrı kesicilerden yeterli fayda görmeyebilir. Geceleri uykudan uyandıran ağrı kötü huylu kemik tümörlerinin bir göstergesi olsa da nadiren iyi huylu tümörde de görülebilir. Vücutta düzensiz sınırlı, hızlı büyüyen ve ağrılı şişlikler ile topallama da kötü huylu olması açısından uyarıcı olmalıdır” diyor.
Erken tanı hayati önem taşıyor!
Sıklıkla 40 yaş sonrası ortaya çıkan kemik metastazı mevcut kanserin ilerlemiş olduğunu gösteriyor. Bu hastaların alanında uzman hekimler (Ortopedik Onkoloji hekimi, Tıbbi ve Radyasyon Onkolojisi, Patoloji, Radyoloji ve Nükleer tıp) tarafından değerlendirilip tanı ve tedavisine karar verilmesi gerekiyor. Doç. Dr. Gümüştaş, kemik metastazlarının tüm kemiklerde gelişebilmekle birlikte en sık omurga, pelvis (leğen kemiği), femur (uyluk) ve humerus (kol) bölgesinde görüldüğünü belirterek şöyle konuşuyor: “ Kemik metastazı tanısının konulmasının hayati önemi vardır. Özellikle kemiğin kendisinden kaynaklanan tümörlerden ve hastanın mevcut tümöründen başka bir odaktan kaynaklanmadığı ortaya konulmalıdır. Aksi taktirde hastanın yaşamını ciddi şekilde olumsuz etkileyecek geri dönüşümsüz hatalara yol açılır.”
Tedavide çok hızlı gelişmeler yaşanıyor
Son yıllarda teknolojideki ve tıp alanındaki hızlı gelişmeler sayesinde kemik metastazlarının tedavisinde çok önemli yenilikler yaşanıyor. Bazı iyi huylu tümörler sadece takip edilirken, birçoğunun ameliyat ile çıkarılmasının tedavi için yeterli olduğunu, kemiğin kendisinden kaynaklanan kötü huylu tümörlerin asıl tedavisinin ise ameliyat ile temiz bir şekilde çıkarılması olacağını vurgulayan Doç. Dr. Gümüştaş sözlerine şöyle devam ediyor: “Bazılarının tedavisinde cerrahiye ek olarak kemoterapi ve/veya radyoterapi uygulanır. Kemik metastazlarının ameliyat ile tedavisinde kapalı ya da açık yöntemler uygulanabilir. Kemik metastazlarının tedavisinde yeni gelişmeler; görüntüleme eşliğinde (tomografi, seyyar röntgen) kapalı uygulanan yakma (radyofrekans ablasyon, mikrodalga ablasyon) ve dondurma (krioablasyon) işlemleridir.”
Tümör yüksek ısıda yakılıyor
Acıbadem Fulya Hastanesi Ortopedi ve Travmatoloji, Ortopedik Onkoloji Uzmanı Doç. Dr. Seyit Ali Gümüştaş, son yıllarda sık kullanılan yöntemlerden Radyofrekans ablasyon (RF) ile bazı iyi huylu kemik tümörleri ve kemik metastazlarının, tümörün görüntüleme eşliğinde yüksek ısıda kapalı olarak yakılması suretiyle tedavi edilebildiğini belirterek “Bu yöntem özellikle genel durumu çok iyi olmayan ve açık cerrahiyi tolere edemeyecek kemik metastazı hastalarında hayati öneme sahiptir. RF ablasyon işlemi çok spesifik olup özellikle kemik ve yumuşak doku tümör cerrahisi ile ilgilenen Ortopedi ve Travmatoloji hekimi ya da Girişimsel Radyologlar tarafından yapılmaktadır” diyor. Doç. Dr. Gümüştaş bu yöntemde ısının tümör üzerinde eritme/küçültme etkisi gösterdiğine, bazen ameliyata gerek bırakmayabildiğine dikkat çekerek “İyi ve kötü huylu kemik tümörlerinde uygulanabilmektedir. Düşük riskli ve hızlı sonuç alınabilen etkin yöntemdir. Radyoterapiye dirençli ya da tekrarlamış kemik metastazlarında uygulanabilmesi ekstra avantajıdır. Seçilmiş hastalarda radyofrekans ablasyon ile tümörü yaktıktan sonra aynı giriş yerinden çimentolama işlemi güvenle uygulanabilir” diye konuşuyor.
Yorumunuz başarıyla alındı, inceleme ardından en kısa sürede yayına alınacaktır.